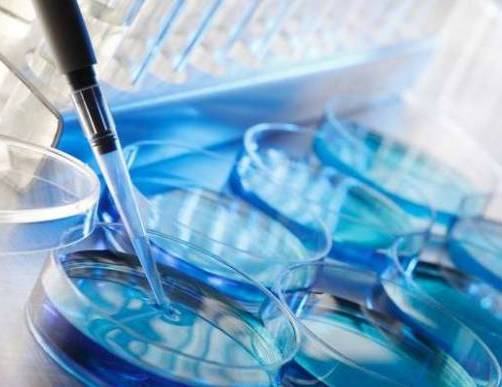

ROMA – Delusioni e disagi per le donne desiderose di ricorrere alla fecondazione eterologa. Secondo quanto riportato da Cittadinanzattiva e ripreso da Repubblica, nonostante il divieto di fecondazione eterologa sia stato cancellato 6 mesi fa, di fatto il servizio pubblico è sostanzialmente fermo. Secondo quanto riporta Repubblica, negli ospedali il trattamento non sarebbe ancora iniziato se non a Firenze -unica eccezione- e non sarà comunque praticato alle donne over 43. In realtà, secondo le linee guida della Conferenza delle Regioni, 43 anni rappresenta il limite del rimborso. In sostanza, chi è più giovane paga il ticket, le altre devono pagare la tariffa piena (fino a 6 mila euro). Solo che in molte Regioni la fecondazione è rifiutata a chi ha oltre 43 anni.
Secondo quanto rivelato da Michele Bocci e Caterina Pasolini per Repubblica, la ragione di questa “tendenza” è di tipo pratico: gli ospedali vorrebbero prima pensare alle coppie coperte dal ticket.
Si legge su Repubblica:
“«Hanno vanificato la sentenza della Corte Costituzionale. Le coppie sono costrette ad andare nel privato o all’estero per fare l’eterologa». A sei mesi dalla caduta del divieto di fecondazione con gameti esterni alla coppia il servizio pubblico è praticamente fermo, come sottolinea l’avvocato Paola Costantini di Cittadinanzattiva. Negli ospedali il trattamento non è iniziato (salvo un caso a Firenze) e soprattutto quasi ovunque non verrà fatto alle coppie con donne di più di 43 anni. Secondo le linee guida della Conferenza delle Regioni quell’età rappresenta il limite alla rimborsabilità della prestazione: sotto si ottiene con il ticket, sopra si dovrebbe pagare la tariffa piena (3.500-6.000 euro). Si dovrebbe, perché in molte Regioni in questi giorni viene deciso di non intervenire comunque su chi ha superato i 43 anni, perché non è il caso che l’ospedale si occupi di prestazioni a pagamento e si vuole pensare prima alle coppie più giovani alle quali per motivi sanitari è stato riconosciuto il diritto a fare il trattamento al costo del ticket”
Eppure secondo gli esperti le donne over 43 che vorrebbero ricorrere alla fecondazione eterologa rappresentano il 70% della domanda totale. Donne che, a questo punto, saranno “costrette” a rivolgersi ai privati (o andare all’estero), come ha denunciato Paolo Costantini di Cittadinanzattiva, secondo cui «la maggioranza delle pazienti saranno escluse dalla sanità pubblica»:
“Ha raccolto la rabbia, il disorientamento delle migliaia di coppie che avevano sperato, dopo il 9 aprile di poter cercare un figlio con donazioni di gameti a pochi passi da casa in un ospedale pubblico. Le sue parole trovano conferma a Milano. Persino dal centro di consulenza genitoriale di Sos infertilità, organizzato con l’appoggio del Comune consigliano «alle coppie di andare oltreconfine ». I motivi? Innanzitutto il limite di 43 anni: «Se è sensato dal punto di vista medico nella fecondazione omologa, perché dopo quell’età c’è poca probabilità che i gameti femminili possano concepire, è assurdo in quella eterologa con donazione di ovociti », sottolinea Rossella Bertolucci”
Non solo: un altro problema è quello delle donazioni:
“Quasi ovunque in Italia non è partita la raccolta di gameti e comunque al momento è molto difficile trovare persone, soprattutto donne, disposte a sottoporsi a trattamento ormonale ed intervento per aiutare chi ha problemi di infertilità. E non è un caso che l’unico trattamento di eterologa eseguito fino ad oggi nel pubblico, all’ospedale di Careggi di Firenze l’altra settimana, sia avvenuto grazie all’acquisizione di liquido seminale da una banca estera. Almeno all’inizio le altre Regioni dovranno percorrere la stessa strada. E c’è un altro problema che riguarda la donazione: i gameti crioconservati in questi anni per trattamenti di fecondazione omologa non si potrebbero usare per fare l’eterologa anche se le donne a cui appartengono vogliono donare. Andrea Borini, presidente della Società italiana di prevenzione della fertilità, fa notare come con le nuove linee guida tra gli esami che devono essere necessariamente fatti ai donatori ci sia il tampone vaginale. «Ma non è mai stato previsto in Italia — dice — e non lo è nelle banche dei tessuti straniere, perché è inutile. Ma averlo richiesto rende inutilizzabili i migliaia di ovociti conservati nelle nostre strutture in questi anni». E ci sono dubbi anche per l’acquisizione all’estero”